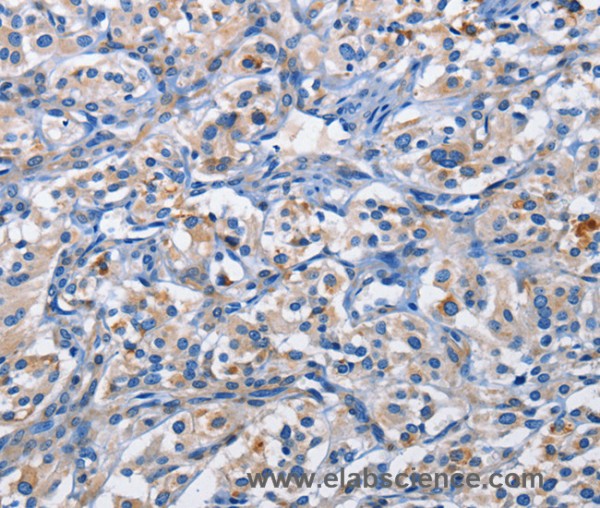
Anti-PIM1

Cookie preferences
This website uses cookies, which are necessary for the technical operation of the website and are always set. Other cookies, which increase the comfort when using this website, are used for direct advertising or to facilitate interaction with other websites and social networks, are only set with your consent.
Configuration
Technically required
These cookies are necessary for the basic functions of the shop.
"Allow all cookies" cookie
"Decline all cookies" cookie
CSRF token
Cookie preferences
Currency change
Customer-specific caching
FACT-Finder tracking
Individual prices
Selected shop
Session
Comfort functions
These cookies are used to make the shopping experience even more appealing, for example for the recognition of the visitor.
Note
Show the facebook fanpage in the right blod sidebar
Statistics & Tracking
Affiliate program
Conversion and usertracking via Google Tag Manager
Track device being used
If you have any questions, please use our Contact Form.
You can also order by e-mail: info@biomol.com
Larger quantity required? Request bulk
You can also order by e-mail: info@biomol.com
Larger quantity required? Request bulk
The protein encoded by this gene belongs to the Ser/Thr protein kinase family, and PIM subfamily.... more
Product information "Anti-PIM1"
The protein encoded by this gene belongs to the Ser/Thr protein kinase family, and PIM subfamily. This gene is expressed primarily in B-lymphoid and myeloid cell lines, and is overexpressed in hematopoietic malignancies and in prostate cancer. It plays a role in signal transduction in blood cells, contributing to both cell proliferation and survival, and thus provides a selective advantage in tumorigenesis. Both the human and orthologous mouse genes have been reported to encode two isoforms (with preferential cellular localization) resulting from the use of alternative in-frame translation initiation codons, the upstream non-AUG (CUG) and downstream AUG codons. Protein function: Proto-oncogene with serine/threonine kinase activity involved in cell survival and cell proliferation and thus providing a selective advantage in tumorigenesis. Exerts its oncogenic activity through: the regulation of MYC transcriptional activity, the regulation of cell cycle progression and by phosphorylation and inhibition of proapoptotic proteins (BAD, MAP3K5, FOXO3). Phosphorylation of MYC leads to an increase of MYC protein stability and thereby an increase of transcriptional activity. The stabilization of MYC exerted by PIM1 might explain partly the strong synergism between these two oncogenes in tumorigenesis. Mediates survival signaling through phosphorylation of BAD, which induces release of the anti-apoptotic protein Bcl- X(L)/BCL2L1. Phosphorylation of MAP3K5, an other proapoptotic protein, by PIM1, significantly decreases MAP3K5 kinase activity and inhibits MAP3K5-mediated phosphorylation of JNK and JNK/p38MAPK subsequently reducing caspase-3 activation and cell apoptosis. Stimulates cell cycle progression at the G1-S and G2-M transitions by phosphorylation of CDC25A and CDC25C. Phosphorylation of CDKN1A, a regulator of cell cycle progression at G1, results in the relocation of CDKN1A to the cytoplasm and enhanced CDKN1A protein stability. Promote cell cycle progression and tumorigenesis by down-regulating expression of a regulator of cell cycle progression, CDKN1B, at both transcriptional and post- translational levels. Phosphorylation of CDKN1B,induces 14-3-3- proteins binding, nuclear export and proteasome-dependent degradation. May affect the structure or silencing of chromatin by phosphorylating HP1 gamma/CBX3. Acts also as a regulator of homing and migration of bone marrow cells involving functional interaction with the CXCL12-CXCR4 signaling axis. [The UniProt Consortium]
| Keywords: | Anti-PIM1, EC=2.7.11.1, Anti-Serine/threonine-protein kinase pim-1, PIM1 Polyclonal Antibody |
| Supplier: | Elabscience |
| Supplier-Nr: | E-AB-14694 |
Properties
| Application: | IHC, ELISA |
| Antibody Type: | Polyclonal |
| Conjugate: | No |
| Host: | Rabbit |
| Species reactivity: | human, mouse, rat |
| Immunogen: | Recombinant protein of human PIM1 |
| Format: | Purified |
Database Information
| KEGG ID : | K04702 | Matching products |
| UniProt ID : | P11309 | Matching products |
| Gene ID : | GeneID 5292 | Matching products |
Handling & Safety
| Storage: | -20°C |
| Shipping: | 4°C (International: -20°C) |
Caution
Our products are for laboratory research use only: Not for administration to humans!
Our products are for laboratory research use only: Not for administration to humans!
Information about the product reference will follow.
more
You will get a certificate here
Viewed



